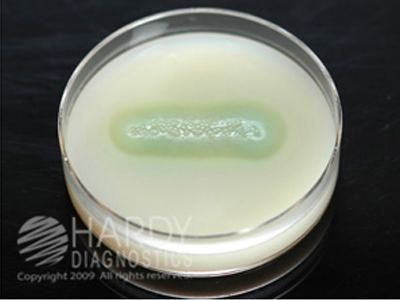

Medium Casein Agar 15x100mm Plate 18 Ml ,Pack Of 10
$ 84.94
|
|
Details:
Casein Agar 18ml^ Casein Agar, 18ml fill, 15x100mm plate, For the differentiation of aerobic actinomycetes based on casein proteolysis. Organisms that can hydrolyse casein, such as Streptomyces, Pseudomonas, will produce a clear halo in the surrounding medium.
Additional Information
| SKU | 24006621 |
|---|---|
| UOM | Pack of 10 |
| UNSPSC | 41106204 |
| Manufacturer Part Number | G122 |
| Product Dimensions | 4X4X8 Inches |
| Product Weight | 0.8 |
